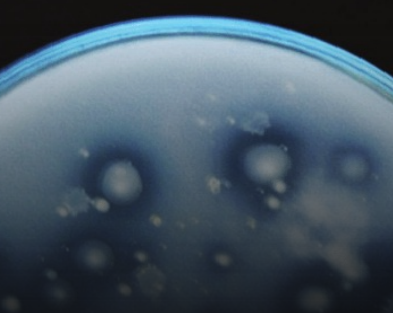
Fósforo

Fósforo (P) na Agricultura: O Nutriente que Mais Limita a ALTA Produtividade?
O Fósforo (P) é reconhecido como um dos nutrientes mais críticos para a agricultura, sendo frequentemente o fator que mais limita a produtividade das culturas, especialmente em solos tropicais e intemperizados.
Sua função vai além da nutrição básica, atuando como um elemento central nos processos energéticos e estruturais da planta.
1. Funções Essenciais do Fósforo na Planta
O Fósforo é indispensável para o ciclo de vida da planta, participando de processos vitais que garantem o desenvolvimento e a produção:
- Armazenamento e Utilização da Energia (ATP): O P é um componente chave da Adenosina Trifosfato (ATP), a molécula responsável por armazenar e transferir a energia captada através da fotossíntese para todas as atividades celulares.
- Crescimento das Raízes: É crucial para o desenvolvimento inicial e contínuo do sistema radicular, garantindo maior capacidade de exploração do solo.
- Maturação e Formação de Estruturas: O nutriente é vital para a maturação dos frutos e para a formação de grãos, frutos e fibras.

2. Informações Importantes Sobre o Fósforo
O manejo do Fósforo é complexo devido à sua dinâmica no sistema solo-planta.
2.1. Absorção por Difusão
O Fósforo entra em contato com a raiz da planta predominantemente via difusão. Este mecanismo, lento por natureza, exige condições específicas para ser eficiente:
- Água no Solo: Essencial para que o P se mova na solução do solo em direção à raiz.
- Concentração de P: Necessidade de uma boa concentração de P na solução do solo.
- Sistema Radicular Ativo: Um sistema radicular bem desenvolvido é fundamental para a interceptação do nutriente.
2.2. Mobilidade e Sintomas de Deficiência
O Fósforo é altamente móvel na planta. Por essa razão, a deficiência ocorre primeiro nas folhas mais velhas, pois a planta remobiliza o nutriente para as partes mais jovens e em crescimento.
2.3. Formas de Absorção e pH
A forma iônica absorvida pela planta é determinada pelo pH do solo:
- Solos Ácidos (Predominantes no Brasil): As plantas absorvem P principalmente como H₂PO₄⁻ (íon ortofosfato primário).
- Solos Alcalinos: A forma absorvida é o HPO₄²⁻ (íon ortofosfato secundário).
A predominância do H₂PO₄⁻ em solos ácidos explica a forte interação do P com elementos de cargas positivas, como o Ferro (Fe) e o Alumínio (Al), formando precipitados que reduzem a disponibilidade do nutriente.
3. Curva de Absorção: A Importância do Estádio Reprodutivo
Um caso interessante de manejo é a curva de absorção em culturas anuais.

Adaptado de: Nutrient Uptake Illustrated for Modern, High-Yielding Soybean" de Barth et al. (2018)
Observação: Grande parte do P em soja e milho é absorvido após o estádio reprodutivo (principalmente depois de R4 e R5).
Este dado demonstra que apenas colocar o P no plantio não garante o aproveitamento total. É preciso manter as raízes vivas por mais tempo e as folhas ativas, com a fotossíntese funcionando de forma eficiente, para que as raízes continuem absorvendo o P nos estágios reprodutivos, quando a demanda para o enchimento de grãos é crítica.
4. Fósforo no Solo: Vias, Frações e o Nível Crítico
Nossos solos, por serem mais intemperizados, são naturalmente pobres em P. O Fósforo presente nos minerais, ao sair das argilas, pode seguir quatro vias principais:
- P Inorgânico: Forma de precipitados (fosfato de Al, fosfato de Fe, fosfato de Ca) ou adsorvido nas argilas.
- Ser Absorvido pelas Plantas.
- Mobilizado pela Microbiota do Solo.
- Forma Orgânica: Incorporado à matéria orgânica.
O P pode também ser exportado pelas plantas (colheita) ou perdido por erosão.
4.1. Fósforo Lábil e Não Lábil
A disponibilidade do P no solo é definida por duas frações:

| Fração do Fósforo | Característica | Implicações para a Planta |
| Fósforo Lábil | Fração prontamente disponível, solúvel em água (íons PO₄³⁻) e facilmente absorvida pelas raízes. | Principal fonte imediata de nutrição para o crescimento das plantas. |
| Fósforo Não Lábil | Fração não imediatamente disponível, ligada a óxidos de Fe e Al ou em compostos orgânicos complexos. | Indisponível a curto prazo, mas atua como reserva de longo prazo. |
4.2. O Processo de Fixação do Fósforo
O P absorvido nas argilas sofre um processo de envelhecimento que fortalece a ligação com o tempo. O P entra em contato com a argila, inicia uma ligação covalente (compartilhamento de elétrons) que se intensifica, chegando ao ponto de o P ficar ocluído dentro da estrutura da argila, tornando a reversão quase impossível.
Por isso, o manejo deve focar em retardar a passagem do P da fração lábil para a não lábil, garantindo que a planta acesse o nutriente por um período maior.
4.3. Nível Crítico e Manejo da Aplicação
O Nível Crítico de um nutriente no solo é o teor em que o solo possui quantidades suficientes para suprir toda a demanda da planta.
- Acima do Nível Crítico: O fertilizante é aplicado em quantidades que visam apenas manter esses níveis no solo, ou aumentar a disponibilidade em casos de cultivos mais tecnificados.
- Abaixo do Nível Crítico: É necessário aplicar o P para construção do teor no solo.

A decisão sobre o método de aplicação deve seguir o Nível Crítico:
- Abaixo do Nível Crítico: O P precisa ser aplicado no sulco de plantio para garantir a máxima proximidade com a raiz em desenvolvimento.
- Acima do Nível Crítico: O P pode ser aplicado a lanço, pois o solo já tem a capacidade de disponibilizar o nutriente no momento necessário.
5. Fatores que Otimizam a Disponibilidade de Fósforo
O manejo eficiente do P depende da correção de fatores limitantes no solo, como pH, compactação e baixa matéria orgânica.
5.1. Influência do Plantio Direto (PD) e Matéria Orgânica (MO)
O Plantio Direto e o aumento da Matéria Orgânica (MO) melhoram significativamente a utilização do P:
- Aumento da CTC e Repulsão: O aumento da MO eleva a Capacidade de Troca Catiônica (CTC) do solo, aumentando as cargas negativas. Isso ocasiona uma repulsão maior das argilas ao H₂PO₄⁻ (que também tem carga negativa), diminuindo a fixação.
- Complexação de Metais: A MO complexa metais como Fe e Al, que poderiam se ligar ao P, tornando-os menos disponíveis para a fixação.
- Redução de Perdas: Diminui as perdas de P por erosão, já que o P na solução do solo seria levado pela chuva em solos descobertos.
- Fósforo Orgânico: A MO (proveniente de plantas de cobertura) é uma fonte de Fósforo orgânico que será mineralizado e disponibilizado gradualmente.
5.2. Influência do pH
A correção do pH é um passo fundamental para a otimização do P:
- Aumento de Cargas Negativas: A elevação do pH aumenta as cargas negativas no solo, promovendo a repulsão da argila ao H₂PO₄⁻.
- Precipitação de Fixadores: A calagem precipita o Al e o Fe, tornando-os menos suscetíveis a se ligarem ao P.
- pH abaixo de 6,0: O P precipita com Fe e Al.
- pH acima de 7,0: O P começa a precipitar com Ca.
- Melhora Radicular: A melhora do pH aumenta o crescimento do sistema radicular, o que, por sua vez, potencializa a absorção de P via difusão.
5.3. Compactação e Oxigenação
A compactação do solo é um grande limitador da absorção de P:
- Resistência Mecânica: Solos compactados limitam o crescimento e a atividade fisiológica das raízes, comprometendo a absorção de P por difusão.
- Deficiência de O₂: A absorção de nutrientes é um processo ativo que exige gasto energético e, consequentemente, oxigênio (respiração). A falta de O₂ impacta a atividade dos transportadores de nutrientes. No caso do Fósforo, a deficiência de oxigênio é ainda mais crítica, pois a difusão é o principal mecanismo de absorção.
Cuidado: A compactação pode estar concentrada na camada de 0–10 cm, mas a análise de solo pode ter sido feita de 0–20 cm, mascarando o problema químico e físico que impede a disponibilidade de nutrientes.
6. O Papel dos Microrganismos e o Uso Foliar
6.1. Microrganismos e a Solubilização de Fósforo
Antes de pensar em microrganismos solubilizadores, é preciso criar um ambiente biológico adequado no solo, que propicie: mineralização da matéria orgânica, crescimento de fungos micorrízicos e desenvolvimento de bioporos.
Regra de Ouro: Não adianta aplicar Fósforo em solo ácido, compactado ou com baixa matéria orgânica. Antes de qualquer adubo, é preciso criar um sistema que propicie a disponibilidade de P para as plantas e que retarde ao máximo as perdas por adsorção e complexação.
A importância dos microrganismos para o acesso ao P é multifatorial:
- Exemplos de Solubilizadores: Bactérias (Bacillus, Pseudomonas, Rhizobium, etc.) e Fungos (Aspergillus e Penicillium).
- Mecanismos:
- Crescimento Radicular: Estimulam o desenvolvimento das raízes.
- Produção de Enzimas: Produzem fosfatases (fitases, nucleases, fosfolipases) que liberam P de compostos orgânicos.
- Produção de Ácidos Orgânicos: Ácidos como glucônico, oxálico, málico e cítrico, que competem com o P pelos sítios de ligação no solo, liberando-o para a solução.
- Produção de Biofilme: O biofilme (à base de polissacarídeos) mantém a rizosfera úmida por mais tempo, aumentando as chances de aquisição de P, já que a absorção se dá por difusão.
6.2. Uso de Fósforo Via Folha
O uso de Fósforo via folha (ex: MAP purificado) pode ser empregado com um objetivo fisiológico, e não apenas nutricional.
A aplicação foliar mantém as folhas mais ativas e acelera enzimas que resultam em um sistema fotossintético mais eficiente. Um sistema fotossintético "redondinho" significa melhor aproveitamento da absorção do P no solo e melhor funcionamento geral da planta.
- Exemplo: Na cultura da soja, 3 aplicações de 2 kg de MAP purificado têm demonstrado boas respostas.
Veja também: Qual Fonte de Fósforo Escolher: Superfosfato Simples ou Triplo?
Referências
Barth, G.; Francisco, E.; Suyama, J. T.; Garcia, F. O. Nutrient Uptake Illustrated for Modern, High-Yielding Soybean. Better Crops with Plant Food, v. 102, n. 1, p. 11-14, 2018.
EMBRAPA. Recomendações de Adubação e Calagem para o Estado de São Paulo. 2. ed. Campinas: Instituto Agronômico, 2020.
IPNI (International Plant Nutrition Institute). O Fósforo e a Produtividade de Culturas. Piracicaba, 2018.
MALAVOLTA, E. Manual de Nutração Mineral de Plantas. São Paulo: Agronômica Ceres, 2006.
RAIJ, B. van. Fertilidade do Solo e Manejo de Nutrientes. Piracicaba: International Plant Nutrition Institute, 2011.